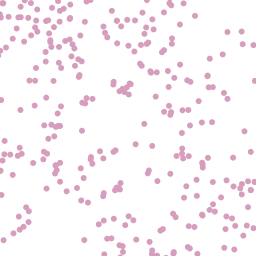

Dienstleistungszentrum des Bundes für … |
|
WMS Geographische Namen 1:250 000
| Service health Now: |
|---|
- Interface
- Web Service, OGC Web Map Service 1.3.0
- Keywords
- GN250, WMS, ViewService, INSPIRE:ViewService, INSPIRE
- Fees
- Die Daten sind urheberrechtlich geschützt. Die Daten werden geldleistungsfrei gemäß der Datenlizenz Deutschland Namensnennung 2.0 (https://www.govdata.de/dl-de/by-2-0) zur Verfügung gestellt. Die Verwendung des Datensatzes für die Pflege und Erweiterung der Daten des OpenStreetMap Projektes wird unter Einhaltung der im Ergänzungstext beschriebenen Angaben zur Namensnennung ausdrücklich erlaubt, siehe https://sg.geodatenzentrum.de/web_public/gdz/lizenz/deu/Datenlizenz_Deutschland_Erg%C3%A4nzungstext_Namensnennung.pdf. Der Quellenvermerk ist zu beachten. || Quellenvermerk: © BKG (Jahr des letzten Datenbezugs) dl-de/by-2-0, Datenquellen: https://sg.geodatenzentrum.de/web_public/Datenquellen_gn250.pdf
- Access constraints
- Es gelten keine Zugriffsbeschränkungen
- Supported languages
- ger
- Data provider
-
Dienstleistungszentrum des Bundes für Geoinformation und Geodäsie (unverified)
Contact information:
Dienstleistungszentrum des Bundes für Geoinformation und Geodäsie
postal:
Karl-Rothe-Str. 10 - 14, 04105 Leipzig, DeutschlandEmail:
Phone: +49 (0) 341 5634 333
- Service metadata
Ads by Google
Die Geographischen Namen umfassen die Namen folgender Objektbereiche: Siedlung, Verkehr, Vegetation, Gewässer, Relief, Gebiete mit Attributen zu: -Administrative Gliederung (statistische Schlüsselzahl) -Flusssystem (Gewässerkennzahl nach LAWA) -Einwohnerzahl -Ortsvorwahl -Größe (Fläche, Länge) -Höhe (Höhe in Metern über NN) -Lage (Geometriedaten aus dem Digitalen Landschaftsmodell im Maßstab 1:250 000) -Status des geographischen Namens -Sprache des geographischen Namens Der Datensatz GN250 orientiert sich am Maßstab 1:250 000 und umfasst ca. 160 000 Einträge. Die Lage der Objekte wird jeweils als Punktgeometrie über eine einzelne Koordinate und über kleinste umschreibende Rechtecke (Bounding Boxes) beschrieben.
Available map layers (4)
Punkte (0)
Punkte
Namen (1)
Namen
Namen (namen)
Punkte (punkte)
There are currently no notifications for the service, click the feed icon to subscribe.